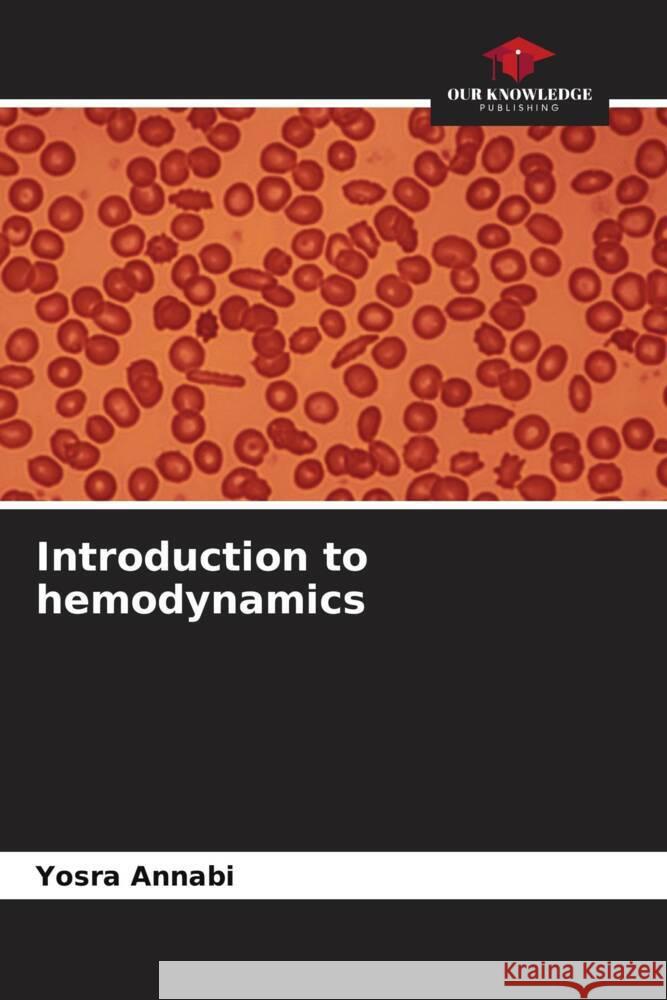
Introduction to hemodynamics Annabi, Yosra 9786205148389 Our Knowledge Publishing - książka

Introduction to hemodynamics » książka
Introduction to hemodynamics
ISBN-13: 9786205148389 / Angielski / Miękka / 72 str.
This book presents a bibliographical work on the modeling of blood dynamics. The first chapter describes the anatomy of the cardiovascular system and the functioning of the blood circulation. The second chapter is devoted to the fluid. It describes the biophysical properties of blood, its composition and the properties of its components. The last two chapters study the flow mechanisms. Thus, the third chapter explains the flow mechanisms of particles in plasma. Some mechanisms are passive like diffusion and osmosis. Others are said to be forced or active such as forced transport because it requires electrochemical energy to occur. The last chapter focuses on the types of blood flow and the energy sources that allow the continuity of blood flow. Generally, blood flow is laminar except in the case of disease. The appendices present real photos of blood vessels of animal origin as well as photos of dissections of animal hearts.